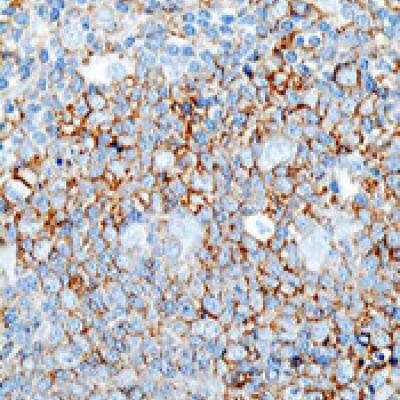

Press release
Global Lymphoma Drugs Market Report 2019 Companies included Celgene, F. Hoffmann-La Roche, Johnson & Johnson, Seattle Genetics and Others
Market Reports Company has recently published 7th edition of Lymphoma Drugs Market Report which covers historic data of year 2013 to 2018 along with a forecast till year 2026.For inquiry or free sample pages email us at: sales@marketreportscompany.com
The report provides a comprehensive view on the current state and future prospects of the market which analyzes different strategies for business growth. The global Lymphoma Drugs market was valued at USD xx Million in 2018 and is anticipated to show significant growth in the near future. In this report, the market can be classified into types, applications, and regions. The report also offers a detailed competitive analysis of all the major players who are active in this market.
Request report sample pages prior purchase@ http://marketreportscompany.com/contact.php
Report Coverage:
•Top Companies
Celgene
F. Hoffmann-La Roche
Johnson & Johnson
Seattle Genetics
Amgen
Bristol-Myers Squibb
Gilead Sciences
GlaxoSmithKline
Novartis
Pfizer
Others (Note: We cover all the Top players actively present in the market and you can also request to profile your competitor's data as a part of report customization without any additional cost)
•Lymphoma Drugs market segments by Type:
HL
NHL
Others
• Lymphoma Drugs market segments by Applications:
Hospitals
Ambulatory Surgical Centers
Others
•Regions covered: (we can provide region/country specific report)
North America (USA, Canada and Mexico)
Europe (Germany, France, UK, Russia, Italy and Others)
Asia-Pacific (China, Japan, Korea, India, Southeast Asia and Others)
South America (Brazil, Argentina, Columbia and Others)
The Middle East and Africa (Saudi Arabia, UAE, Egypt, Nigeria, South Africa and Others)
(Note: We can provide country or region specific report on request; please contact us at sales@marketreportscompany.com )
Our reports are designed keeping in mind the need of all members across the value chain. However, if any
particular pointer needs to covered to meet your specific requirements, we can provide a customized
report. The below mentioned customization pointers are available for the report.
● Detailed Analysis for additional company profiles
● Specific Country Level breakdown by Application and type
● Additional Segment Analysis
● Others
The said report has been derived by findings drawn from thorough primary research and secondary research. The report covers complete quantitative and qualitative information by analyzing data collected by prominent players across key points in the industry’s value chain.
How helpful this report will be?
• In depth analysis on emerging regions, types & Application, and competitive landscape
• Key parameters which are driving market and restraining market growth.
• The report will help you understand Industry Dynamics, Market Size and Forecast, Market Entry
Strategy, Competitive Intelligence, Pricing Analysis, Consumer Insights, Procurement Intelligence,
Next-generation Technologies, etc.
Purchase Inquire before Buying @ http://marketreportscompany.com/contact.php
Table of Content:
(Request detailed TOC @sales@marketreportscompany.com)
Global Lymphoma Drugs Market Size, Status and Forecast 2026
1 Industry Overview of Global Lymphoma Drugs
2 Global Lymphoma Drugs Competition Analysis by Players
3 Company (Top Players) Profiles
4 Global Lymphoma Drugs Market Size by Type and Application (2013-2019)
5 Development Status and Outlook…
11 Market Forecast by Regions, Type and Application (2019-2026)
12 Global Lymphoma Drugs Market Dynamics
12.1 Global Lymphoma Drugs Industry News
12.2 Global Lymphoma Drugs Industry Development Challenges
12.3 Global Lymphoma Drugs Industry Development Opportunities (2019-2026)
13 Market Effect Factors Analysis
14 Global Lymphoma Drugs Market Forecast (2019-2026)
15 Research Finding/Conclusion
16 Appendix........................to receive complete Table of Content @ http://marketreportscompany.com/contact.php
What Does Report Include?
Historic Data: What was the Lymphoma Drugs Market data (Size, competition, company share, YoY growth rate, etc.) from 2013 to 2019.
Current Market Status: A comprehensive analysis of current market Size, trends, growth drivers, industry pitfalls, challenges and opportunities for players.
Market Forecast: Report will comment and provide details about market growth and forecast till the year 2025.
Customization: We can provide following things 1) On request more company profiles (competitors) 2) Data about a particular country or region 3) We will incorporate the same with no additional cost (Post conducting feasibility).
About us: http://marketreportscompany.com/about-us.php
Contact Us:
Jason Smith,
Sales Manager, Global Business Development,
Website: marketreportscompany.com
Email: jasonsmith@marketreportscompany.com
Phone: +1-312-376-8303
Address: 20 N State Street,
Chicago, Illinois, 60602
United States
This release was published on openPR.
Permanent link to this press release:
Copy
Please set a link in the press area of your homepage to this press release on openPR. openPR disclaims liability for any content contained in this release.
You can edit or delete your press release Global Lymphoma Drugs Market Report 2019 Companies included Celgene, F. Hoffmann-La Roche, Johnson & Johnson, Seattle Genetics and Others here
News-ID: 1617050 • Views: …
More Releases for Application
Email Application Market Size Analysis by Application, Type, and Region: Forecas …
According to Market Research Intellect, the global Email Application market under the Internet, Communication and Technology category is expected to register notable growth from 2025 to 2032. Key drivers such as advancing technologies, changing consumer behavior, and evolving market dynamics are poised to shape the trajectory of this market throughout the forecast period.
The Email Application Market is growing quickly because more and more people and businesses need to be able…
Travel Application Market Size Analysis by Application, Type, and Region: Foreca …
USA, New Jersey- According to Market Research Intellect, the global Travel Application market in the Internet, Communication and Technology category is projected to witness significant growth from 2025 to 2032. Market dynamics, technological advancements, and evolving consumer demand are expected to drive expansion during this period.
Due to the growing need for digital travel solutions and the growing usage of smartphones, the travel application industry is growing quickly. Travellers' preference…
Web Application Development Company Creates Application Replatforming Guide
Image: https://www.getnews.info/wp-content/uploads/2024/09/1725267563.jpeg
Orases, a custom software development company located in Frederick, MD, has recently unveiled its new "Application Replatforming Guide." This comprehensive guide is designed to help businesses understand the importance of modernizing their legacy systems and provides a step-by-step approach to successfully execute replatforming projects.
Frederick, Maryland - September 2, 2024 - Orases, a Frederick-based application replatforming agency [https://orases.com/replatforming/], is excited to announce the release of its latest resource, the…
POS Printer Market Report 2018: Segmentation by Type (Impact, Thermal, Others) b …
Global POS Printer market research report provides company profile for Bixolon, Boca Systems, Cognitive TPG, CUSTOM SPA, NCR, Pertech Industries, Woosim, Zebra and Others.
This market study includes data about consumer perspective, comprehensive analysis, statistics, market share, company performances (Stocks), historical analysis 2012 to 2017, market forecast 2018 to 2025 in terms of volume, revenue, YOY growth rate, and CAGR for the year 2018 to 2025, etc. The report also…
High Voltage Super Junction MOSFET Market Report 2018: Segmentation by Type (SMT …
Global High Voltage Super Junction MOSFET market research report provides company profile for Fuji Electric, IceMOS Technology, ROHM, Vishay, DACO Semicondusctor, STMicroelectronics, Renesas Electronics, ON Semiconductor (Fairchild Semiconductor), Alpha & Omega Semiconductor, Infineon Technologies Toshiba and Others.
This market study includes data about consumer perspective, comprehensive analysis, statistics, market share, company performances (Stocks), historical analysis 2012 to 2017, market forecast 2018 to 2025 in terms of volume, revenue, YOY growth…
Waste to Energy Market Report 2018: Segmentation by Technology (Thermal, Biologi …
Global Waste to Energy market research report provides company profile for Waste Management Inc., Suez Environment S.A., C&G Environmental Protection Holdings, Constructions industrielles de la Mediterranee (CNIM), China Everbright International Limited, Covanta Energy Corporation, Foster Wheeler A.G., Abu Dhabi National Energy Company PJSC and Others.
This market study includes data about consumer perspective, comprehensive analysis, statistics, market share, company performances (Stocks), historical analysis 2012 to 2017, market forecast 2018 to…